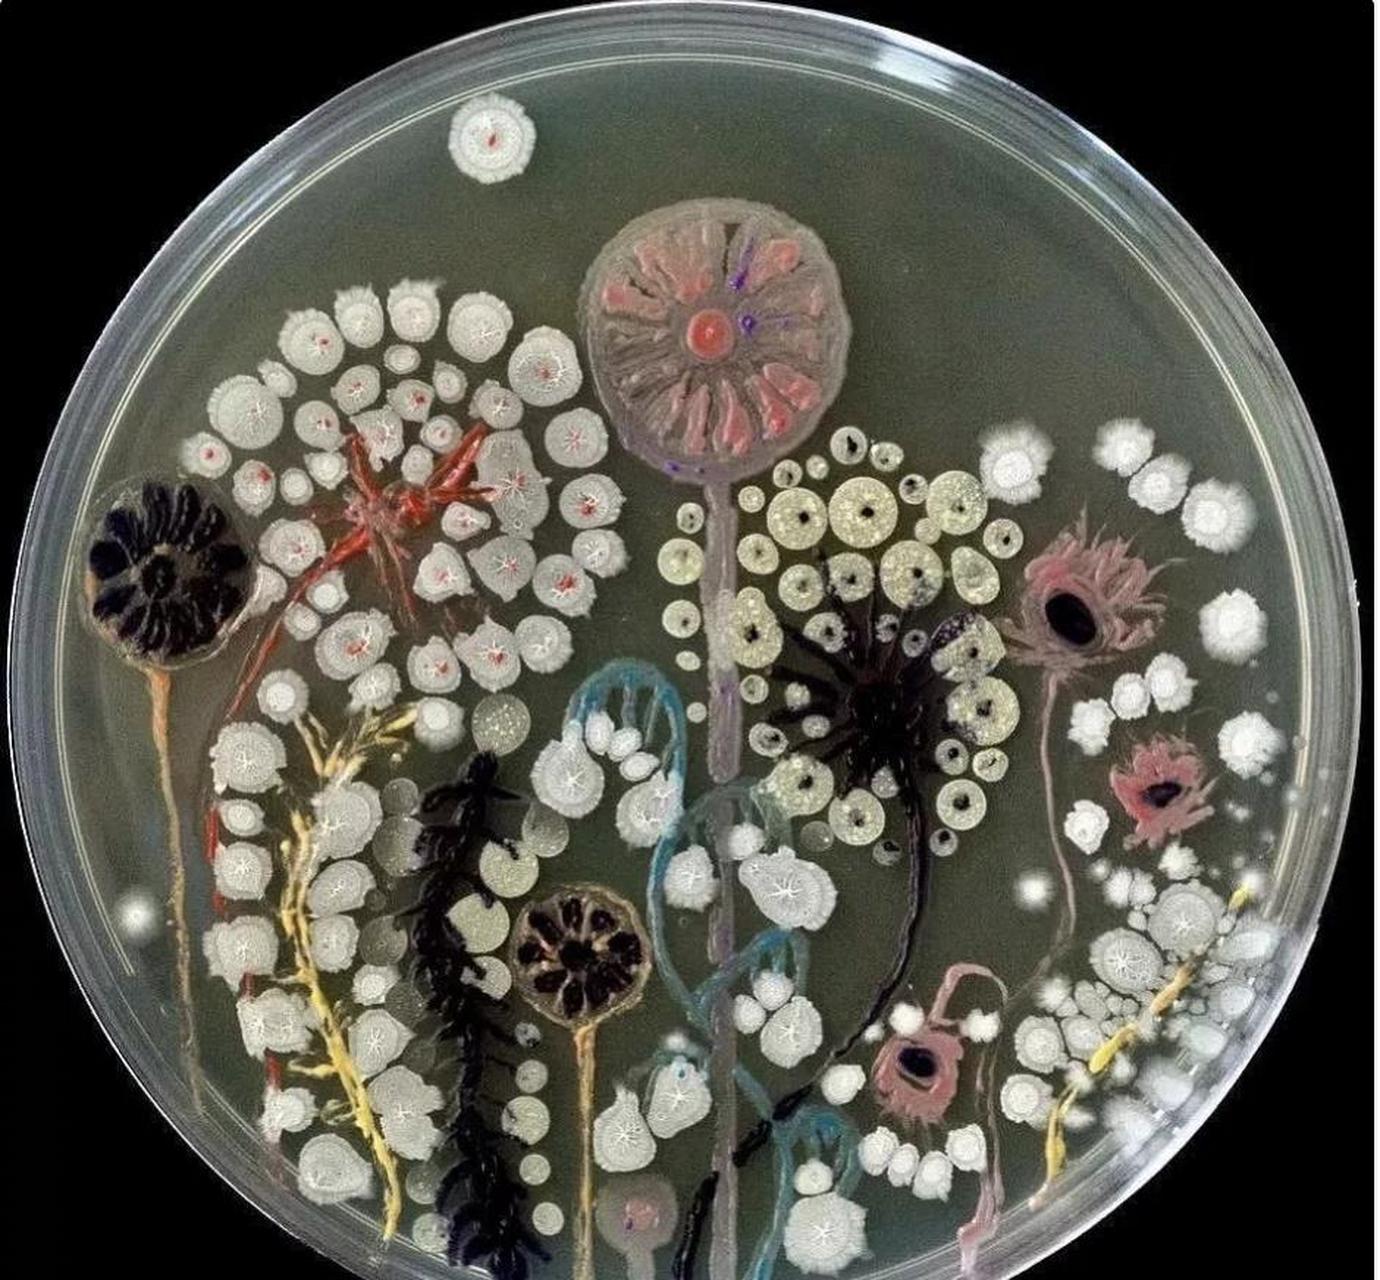
一周愉快!细菌画

细菌画

细菌画 - 美篇
图片尺寸3150x2186
细菌的简笔画 细菌的简笔画q版 | 多想派
图片尺寸500x500
细菌节细菌简笔画 简笔画图片大全-蒲城教育文学网
图片尺寸500x669
病毒细菌简笔画消灭 简笔画图片大全-蒲城教育文学网
图片尺寸525x300
细菌图图片-细菌图素材-细菌图插画-摄图新视界
图片尺寸300x300
细菌简笔画 细菌简笔画图片 - 水彩迷
图片尺寸1024x724
#儿童画素材##儿童画教程##创意美术##绘画##儿童创意美术#
图片尺寸626x626
细菌作画 - 美篇
图片尺寸747x1175
细菌简笔画简单又漂亮 简笔画图片大全-蒲城教育文学网
图片尺寸500x500
手绘细菌图片免费下载_卡通手绘_万素网
图片尺寸700x595
小细菌简笔画 简笔画图片大全-蒲城教育文学网
图片尺寸500x500
一周愉快!细菌画
图片尺寸1380x1280
#儿童画素材##儿童画教程##创意美术##绘画##儿童创意美术#
图片尺寸500x500
细菌也能作画?看看理科生的艺术细"菌" - 德元国际-北京德元国际科技
图片尺寸640x577
细菌传播方式图片-细菌传播方式素材下载-众图网
图片尺寸539x812
水果大战细菌简笔画 简笔画图片大全-蒲城教育文学网
图片尺寸461x450
细菌的简笔画怎么画-百度经验
图片尺寸500x255
细菌的简笔画 细菌的简笔画q版 | 第 3 页
图片尺寸519x500
细菌图片简笔画 细菌图片简笔画 | 第 2 页
图片尺寸1000x1000
细菌图片简笔画 细菌图片简笔画_牛求艺网
图片尺寸999x625
猜你喜欢:细菌创意画细菌简笔画图片大全儿童画细菌细菌画 可爱小细菌简笔画简笔画细菌细菌画简笔画病毒细菌可爱简笔画细菌怎么画细菌简笔画细菌怎么画简笔画细菌怎么画简单细菌怎么画简单画法细菌怎么画美术细菌怎么画儿童细菌怎么画可爱细菌怎么画创意细菌怎么画世界细菌怎么画病毒细菌怎么画卡通细菌细菌怎么画大王细菌怎么画简单可怕蓝细菌细菌怎么画简单又可爱细菌怎么画大作战细菌卡通细菌图片细菌怎么画历险记细菌结构丙酮分子式bareknuckle吓得瑟瑟发抖表情包林珍娜killit剧照大象吃东西山鹿茸图片大全星之守护者阿狸手办鬼刀小绿高清电脑壁纸小雏菊清新乱扔垃圾的图片漫画凹凸世界之自然少女小学美术线条的魅力ppt